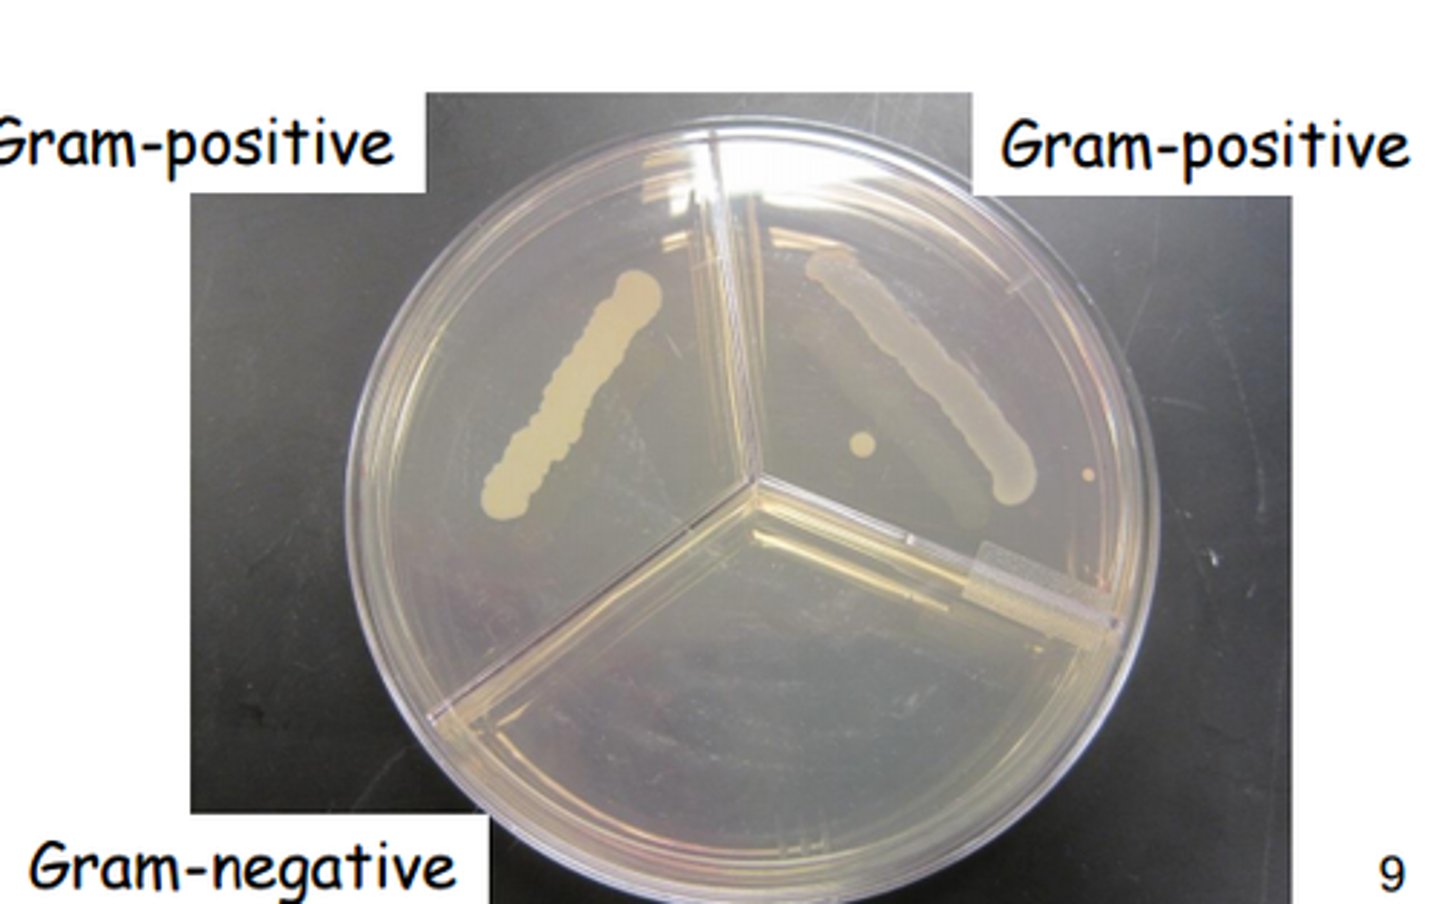
<p>What does Phenylethyl alcohol agar (PEA) select for?</p>
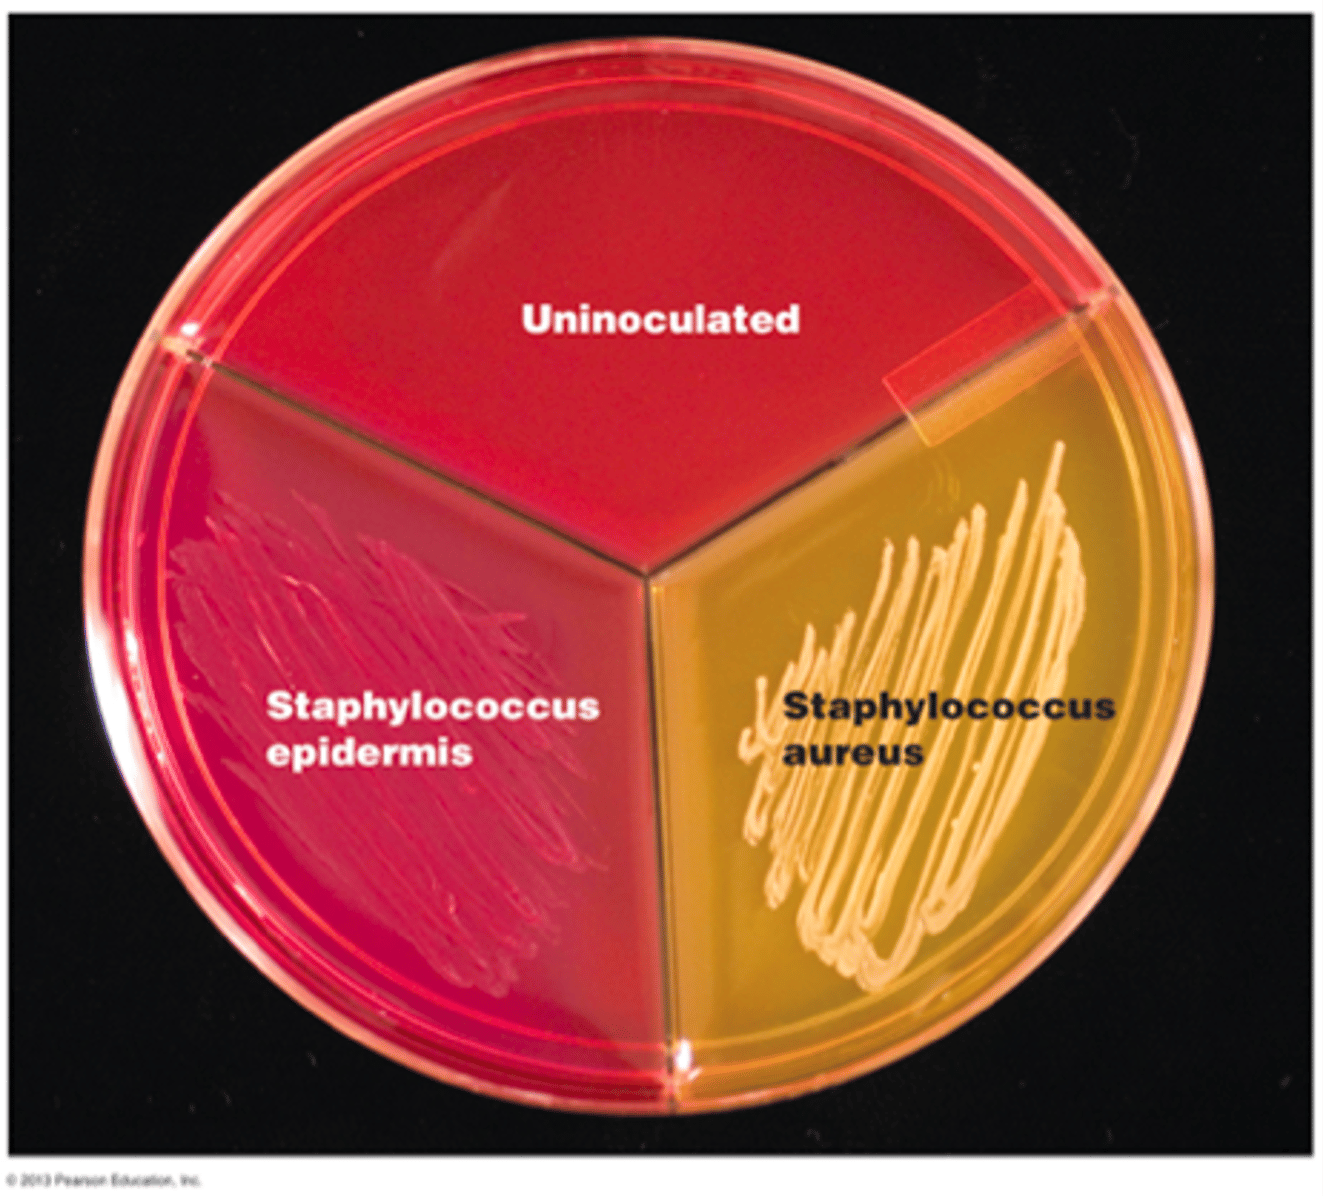
<p>What are the expected results of Staph epi streaking on an MSA plate?</p>
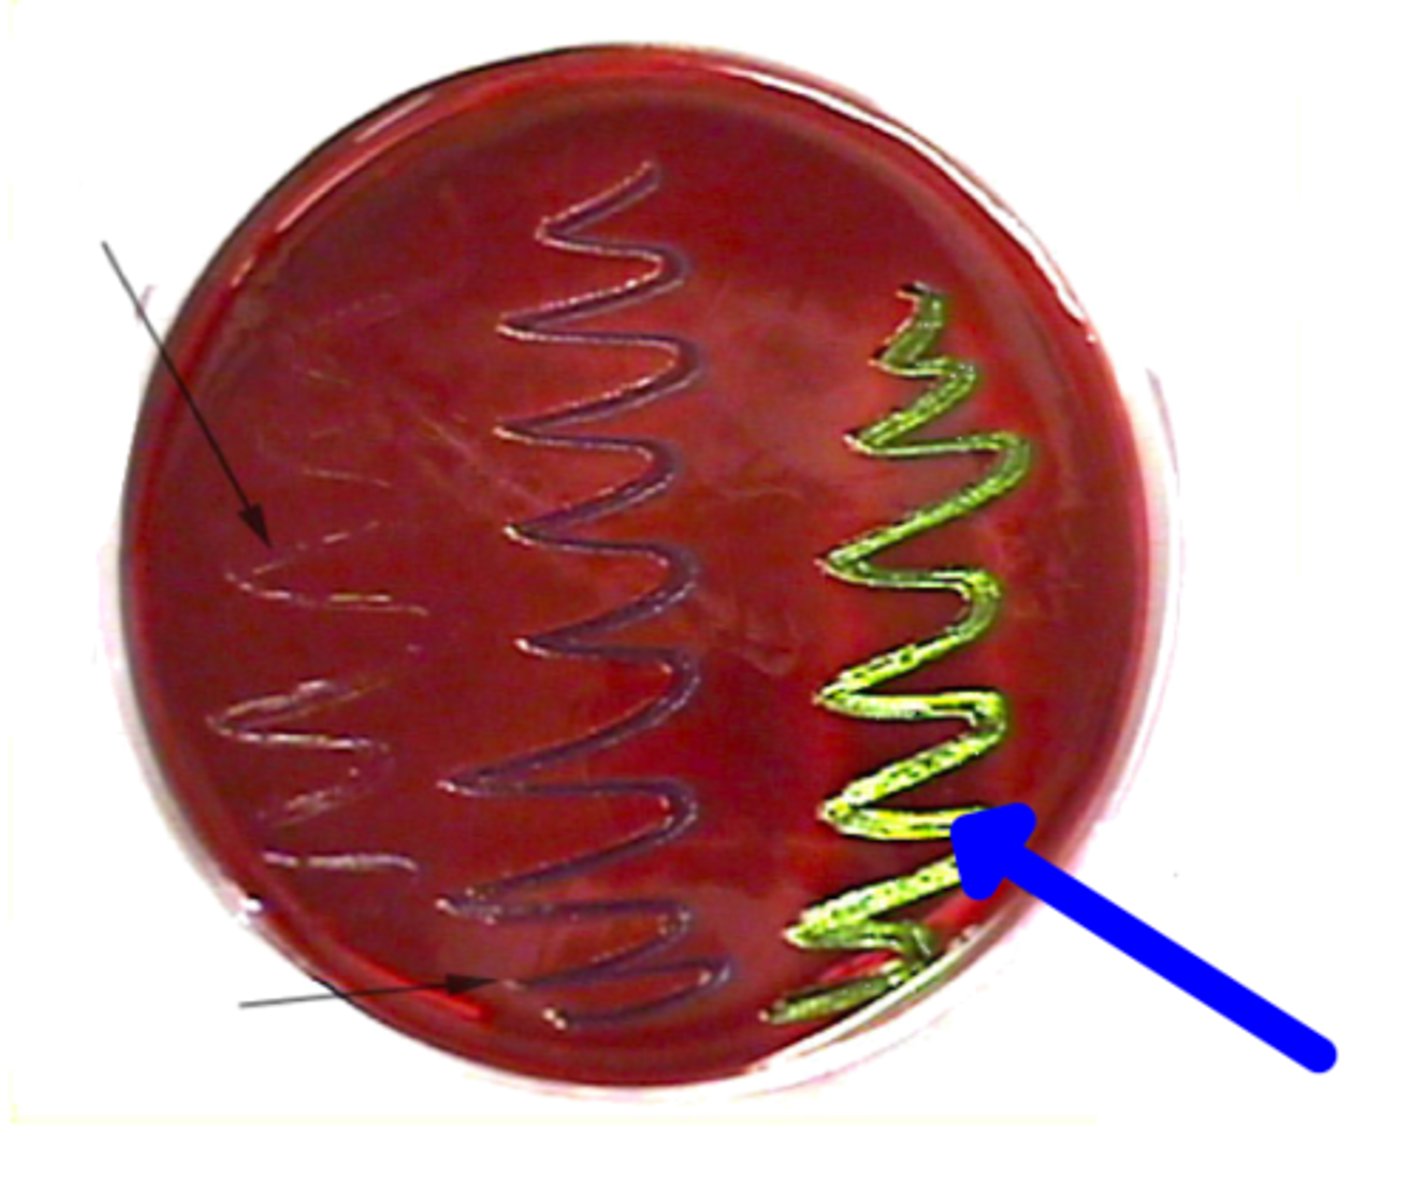
<p>a group of aerobic or facultatively anaerobic, Gram-negative, non-endospore forming rods that ferment glucose</p>

IU M215 Lab Practical
1/135
There's no tags or description
Looks like no tags are added yet.
Name | Mastery | Learn | Test | Matching | Spaced | Call with Kai |
|---|
No analytics yet
Send a link to your students to track their progress
136 Terms
illuminator
what is this?

condenser
what is this?

iris diaphragm
what is this?

objective lens
what is this?

ocular lens
what is this?

coarse adjustment knob
what is this?

fine adjustment knob
what is this?

40x
The 4x objective lens is really ________________ magnification.
100x
The 10x objective lens is really ________________ magnification.
400x
The 40x objective lens is really ________________ magnification.
1000x
The 100x objective lens is really ________________ magnification.
aseptic
without contamination
agar
a solidifying agent that forms a semi-solid at room temperature

agar slants
solidify with the tube at an angle (hence the name), creating a large, solid surface area to support growth and provide useful short-term storage of cultures

agar deeps
support the growth of microbes at a range of oxygen concentrations since the solidified medium acts as a barrier to atmospheric oxygen at depths below the surface.

inoculating loop
a device used to aseptically transfer and streak microbes in the laboratory

inoculating needle
Used to transfer a culture (by stabbing) to a semisolid medium like motility agar; used to inoculate a deep media

By placing the loop or needle into the Bunsen burner until it is red hot
how do you sterilize loops and needles?
in the hospital, to prevent healthcare-associated infections
why are hand-washing and aseptic technique important?
simple stain
The process by which a single stain is used to color the cells

gram stain
A classic technique used to differentiate bacteria and identify the causative agent of infection. This technique exploits structural differences in the peptidoglycan cell wall to separate bacteria into two groups, Gram-positive and Gram-negative.

gram-positive bacteria
Bacteria that have a thick peptidoglycan cell wall, and no outer membrane. They stain very darkly (purple) in Gram stain.

gram-negative bacteria
Bacteria that have a thin peptidoglycan cell wall covered by an outer plasma membrane. They stain very lightly (pink) in Gram stain.

crystal violet, iodine, alcohol, safranin
what are the steps of the gram stain?

crystal violet
primary stain in gram stain

iodine
mordant in gram stain

ethyl alcohol
decolorizer in gram stain

safranin
counter stain in gram stain

To fix specimen to slide and to kill the bacteria.
what is the purpose of heat fixing?

bacillus
which bacterium can have mixed gram reaction?

Neisseria (meningitidis)
what is the only gram-negative cocci that we have covered in lab?
Streptococcus pneumoniae
what is an example of a gram-positive cocci (streptococci)?
bacillus
rod-shaped bacterium

cocci
sphere shaped bacteria

both gram-negative and gram-positive bacteria will appear purple
If you forget to add the decoloring agent, what will happen?
it lightly colors Gram-negative cells pink so they can also be observed
purpose of safranin?
psychrophiles
cold-loving bacteria that exhibit an optimal growth temperature of less than 15°C
mesophiles
grow best at a temperature range of 20°C to 45°C
thermophiles and hyperthermophiles
thrive and grow at temperatures ranging from 45°C to temperatures exceeding 100°C, well above optimal for most organisms
psychotrophs
demonstrate growth at temperatures higher than psychrophiles: greater than 15°C for optimal growth and greater than 20°C for maximum growth temperature
obligate anaerobes
organisms that cannot live where molecular oxygen is present
obligate aerobes
require oxygen
facultative anaerobes
can survive with or without oxygen
microaerophiles
can use oxygen only when it is present at levels reduced from that in air
facultative anaerobe
what type of aerobic/anaerobic bacteria is e. coli?

strict aerobe
bacterial growth is concentrated at the surface, where oxygen levels are the highest

strict anaerobe
bacterial growth is concentrated well below the surface of the agar, where oxygen levels are the lowest

facultative anaerobe
bacterial growth is found throughout the medium, with a majority concentrated in the oxygen-rich top

microaerophile
bacterial growth is concentrated just below the surface of the agar, where oxygen is present but at a lower concentration compared to the surface

thioglycolate media
combines with oxygen to create anaerobic or microaerobic conditions

osmotic pressure
pressure that must be applied to prevent osmotic movement across a selectively permeable membrane
bacteria
________________ with their peptidoglycan cell wall are immune to the effects of rapid water uptake
halophile
"salt-loving" bacteria that live in environments that have very high salt concentrations
falcultative halophile
salt tolerant microorganisms that grow at both low and high salt concentrations
Staphylococcus epidermidis
this is a common halotolerant bacteria

E. coli
this is a halo INTOLERANT bacteria (right side of image)

neutrophile
an organism that grows best at neutral pH, between pH 5.5 and 8
acidophile
an organism that grows best at low pH; typically below pH 6
alkaliphile
an organism that has a growth pH optimum of 8 or higher
lactobacillus lactis
this bacteria is an acidophile
E. coli
this bacteria is a neutrophile
Alcaligenes faecalis
this bacteria is an alkaliphile (or at least alkali-tolerant)
anaerobic jar
Used to create anaerobic, microaerophilic, CO2-enriched
conditions depending on specific needs of bacteria being cultivated

gaspak
anaerobic jar, H2 produced to combine with O2 to form water; should be colorless in absence of oxygen; also used in place of Brewers anaerobic agar
bacteriostatic
inhibits/slows bacterial growth
bactericidal
kills bacteria
disinfectant
antimicrobial agent used on inanimate surfaces like sinks, toilets, and floors to remove or reduce the number of microorganisms
filter-paper disk method
Method of evaluating the antimicrobial properties of a chemical agent using filter paper disks placed on an inoculated agar plate

zone of inhibition
Region around a chemical saturated disc, where bacteria are unable to grow due to adverse effects of the compound in the disc.

1. hydrogen peroxide
2. bleach
3. isopropyl alcohol
order these three antibacterial agents from least to most effective (smallest to largest zone of inhibition):
- bleach, isopropyl alcohol, hydrogen peroxide
Bacillus subtilis
what is a bacteria that we have worked with that forms endospores?
Kirby-Bauer Test
The test to determine the efficacy of antibiotics or the antibiotic resistance of bacteria.

bigger
The more susceptible a bacteria is to an antibiotic, the _____________ the zone of inhibition
streak-plate isolation
Method used to separate a mixed culture and develop isolated colonies

colony morphology
What is one of the most valuable pieces of information provided by streak-plate isolation?

selective medium
a culture medium with an ingredient that inhibits the growth of microbes other than the one being sought
1. select for the growth of one microbe
2. inhibit the growth of any other microbes
what are the two purposes of a selective medium?
Gram-positive cocci
What does Phenylethyl alcohol agar (PEA) select for?
phenylethyl alcohol
What is the selective medium in the PEA medium?
halophilic Staphylococcus spp
What does the Mannitol Salt Agar (MSA) select for?

Selective:
- has 7.5% NaCl, which inhibits the growth of non-halophiles and selects for halophiles such as staphylococcus spp.
Differential:
- includes the pH indicator phenol red, which differentiates bacteria based on their ability to ferment the carbohydrate mannitol.
What makes the MSA plate selective AND differential?
red-to-yellow color change, due to acid production and mannitol fermentation
What are the expected results of Staph aureus streaking on an MSA plate?

shows up but with no color change, since staph epi does not ferment mannitol
What are the expected results of Staph epi streaking on an MSA plate?
fecal coliforms
What does the Eosin-Methylene Blue Agar (EMB) agar attempt to identify?

fecal coliform
a group of aerobic or facultatively anaerobic, Gram-negative, non-endospore forming rods that ferment glucose
Selective:
- based on the presence of two dyes, eosin and methylene blue, that moderately inhibit the growth of Gram-positive bacteria
Differential:
- based on their ability to ferment lactose
What makes the Eosin-Methylene Blue Agar (EMB) selective AND differential?
rapid - dark purple or black with a metallic green sheen
weak - bright pink to purple growth
What colors will rapid (strong) and weak lactose fermenters turn on a eosin-methylene blue agar?

fecal coliforms from feces
What does the MacConkey agar (MAC) attempt to identify?

Selective:
- the inclusion of crystal violet and bile salts, which inhibit the growth of Gram-positive bacteria
Differential:
- based on their capacity to ferment lactose, and the pH indicator neutral red
What makes MacConkey agar (MAC) selective AND differential?
no
Will the medium (on the MAC agar) change colors if there is no lactose fermentation?
1. gram-negative, non-lactose fermenter (no color change)
2. gram-negative, lactose fermenter (pink color change)
What are the two results that you can get from the MacConkey agar experiment?

fastidious bacteria, including members of the genus Streptococcus
What does blood agar attempt to identify?

Enriched:
- enriched with sheep’s blood to promote the growth of Streptococcus spp
Differential:
- separates bacteria based on their ability to lyse red blood cells.
What makes blood agar enriched and differential?
1. beta-hemolysis
2. alpha-hemolysis
3. gamma-hemolysis
What are the three types of hemolysis observed in blood agar?
beta-hemolysis
- loss of red coloration due to complete destruction of RBCs
alpha-hemolysis
- green coloration due to partial destruction and hemoglobin oxidation
gamma-hemolysis
- no color change due to no destruction
What do the results of each type of hemolysis look like on the blood agar?

autoclave
how is media sterilized?

how to use a pipette
1. Apply a new tip to the pipette
2. Press to 1st stop and release to draw liquid in
3. Press to 2nd stop to expel liquid
4. Remove from sample before you release!
5. Press button to eject tip

serial dilution
Dilution of a substance several times by the same amount each time

1. grab a certain number of tubes (ex. 4) and label them
2. add a sterile dilutant to each of the tubes
3. add a bacteria culture to the first tube
4. mix the tube by flicking or making a vortex
5. take 1 mL from that tube and add it to the next, repeating this step until you get to the last tube.
how do you complete a serial dilution?
Number of colonies/volume plated (mL) x dilution factor
what is the formula for CFU/mL of cultures?